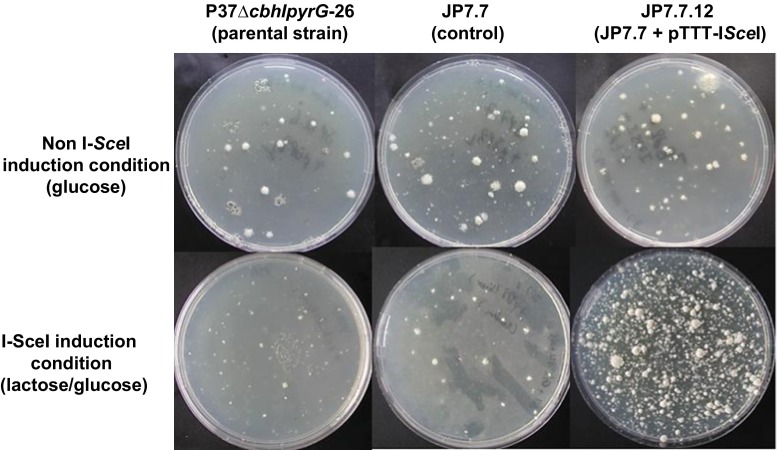

Abstract
Targeted integration of expression cassettes for enzyme production in industrial microorganisms is desirable especially when enzyme variants are screened for improved enzymatic properties. However, currently used methods for targeted integration are inefficient and result in low transformation frequencies. In this study, we expressed the Saccharomyces cerevisiae I-SceI meganuclease to generate double-strand breaks at a defined locus in the Trichoderma reesei genome. We showed that the double-strand DNA breaks mediated by I-SceI can be efficiently repaired when an exogenous DNA cassette flanked by regions homologous to the I-SceI landing locus was added during transformation. Transformation efficiencies increased approximately sixfold compared to control transformation. Analysis of the transformants obtained via I-SceI-mediated gene targeting showed that about two thirds of the transformants resulted from a homologous recombination event at the predetermined locus. Counter selection of the transformants for the loss of the pyrG marker upon integration of the DNA cassette showed that almost all of the clones contained the cassette at the predetermined locus. Analysis of independently obtained transformants using targeted integration of a glucoamylase expression cassette demonstrated that glucoamylase production among the transformants was high and showing limited variation. In conclusion, the gene targeting system developed in this study significantly increases transformation efficiency as well as homologous recombination efficiency and omits the use of Δku70 strains. It is also suitable for high-throughput screening of enzyme variants or gene libraries in T. reesei.
Electronic supplementary material
The online version of this article (doi:10.1007/s00253-015-6829-1) contains supplementary material, which is available to authorized users.
Keywords: Meganuclease, DNA repair, Counter selection, Targeted integration, Hypocrea jecorina
Introduction
Trichoderma reesei (teleomorph Hypocrea jecorina) can secrete large amounts of extracellular protein (up to 100 g/L), which makes it a paradigm host for homologous and heterologous protein production (Anderson et al. 2013; Schuster and Schmoll 2010). To improve production, activity or other properties of industrially interesting enzymes, both random and systematic approaches to generate enzyme variants are employed (Adrio and Demain 2014; Turner 2009). To simplify comparison among enzyme variants or different homologues expressed in filamentous fungi and, in particular T. reesei, it is highly desirable that in order to ensure an identical genetic environment, the corresponding DNA constructs are integrated at a defined locus in the genome. Random integration of expression cassettes often leads to significant variation in production levels caused by differences in copy number and/or sites of integration. Therefore, it has been attempted to increase the efficiency of gene targeting in T. reesei by several means, such as by increasing the size of the region homologous to the target locus (Catalano et al. 2011) or by developing strains that are deficient in non-homologous end joining (NHEJ) (Catalano et al. 2011; Guangtao et al. 2009). However, even though the efficiency of homologous integration events is tremendously increased in strains deficient in NHEJ, it remains highly locus-dependent (Schuster et al. 2012). Transformation frequencies with NHEJ-deficient strains are often low, making it difficult and laborious to generate enough mutants for library screening. Consequently, there is still a need to develop alternative methods for efficient gene targeting into the genome of T. reesei that lead to high homogeneity in protein expression among transformants. Another limiting factor associated with T. reesei transformation is a relative low frequency of stable, DNA integration events. A substantial number of primary transformants (30–50 %) are abortive ones, in which a plasmid is only transiently expressed and not integrated into the genome.
In this study, we present an approach that not only increases the number of stable transformants in T. reesei up to sixfold but also increases the efficiency of targeted integration of the gene of interest. The approach is based on stimulating the formation of a DNA double-strand break (DSB) at a specific locus of the genome, which is subsequently efficiently repaired by the receiving organism to maintain its genomic integrity and survival (Bollag et al. 1989; Szostak et al. 1983). Eukaryotic cells repair DSBs either by the NHEJ pathway or via homology directed repair (HDR) with homologous sequences flanking the DSBs or any other available homologous template, including exogenous donor sequences (Cahill et al. 2006). Genomic DSBs can occur either naturally or be induced artificially. It has been shown that DSBs can be specifically induced in eukaryotic genomes by using the yeast I-SceI endonuclease (Arazoe et al. 2014; Choulika et al. 1995; Kuijpers et al. 2013; Puchta et al. 1993; Rouet et al. 1994). I-SceI is a mitochondrial homing endonuclease encoded by the Saccharomyces cerevisiase mitochondrial genome and recognizes a 18-basepair-long DNA sequence (5′-TAGGGATAACAGGGTAAT-3′) (Monteilhet et al. 1990; Plessis et al. 1992; Fairhead and Dujon 1993). Since the recognition site is rather long and specific, I-SceI recognition sites are absent in most eukaryotic genomes, including the T. reesei genome. Expression of the endonuclease I-SceI has been previously demonstrated to efficiently induce DSBs at I-SceI sites inserted at specific sites in prokaryotic cells (Meddows et al. 2005) and also in several eukaryotes, including mammalian cells (Choulika et al. 1995), plants (Puchta et al. 1993) and unicellular eukaryotes (Glover and Horn 2009). In filamentous fungi, I-SceI-mediated DSBs have been recently described in Pyricularia oryzae (Arazoe et al. 2014), a fungus belonging to the class of Sordariomycetes, to which T. reesei also belongs. In the present report, we have introduced I-SceI recognition sites into the genome of T. reesei and have investigated the effect of DSBs mediated by heterologous expression of I-SceI on transformation efficiency, on frequency of targeted integration of a reporter gene and on the expression levels of the reporter protein. We have also shown that about two thirds of the transformants integrated a reporter T. reesei glucoamylase gene at a pre-assigned locus and expressed it uniformly.
Materials and methods
Strains and cultivation conditions
T. reesei strain RL-P37∆cbhIpyrG-26 (from DuPont Industrial Bioscience division, Leiden, The Netherlands) was used as a parental strain throughout the study. RL-P37∆cbhIpyrG-26 was developed from the wild-type T. reesei strain, QM6a, via several classical mutagenesis steps and was modified to delete the gene encoding cellobiohydrolase 1 (Cbh1) and inactivate the pyr4 gene. T. reesei strains derived from the parental strain and used in this study are listed in Table 1. T. reesei strains were maintained on Trichoderma agar minimal medium (TrMM) containing 15 g/L KH2PO4, 5 g/L (NH4)2SO4, 20 g/L carbon source (glucose or lactose), 0.6 g/L MgSO4·7H2O, 0.6 g/L (mM) CaCl2·2H2O, 1 mL/L trace element solution (175 g/L C6H8O7, 200 g/L FeSO4·7H2O, 16 g/L ZnSO4·7H2O, 3.2 g/L CuSO4·5H2O, 1.4 g/L MnSO4·H2O and 0.8 g/L H3BO3) and 2 % agar and set at pH 4.8. When required, the medium was supplemented with 10 mM uridine or 10 mM acetamide instead of (NH4)2SO4 (for amdS selection) or 5 μg/ml of chlorimuron ethyl (for acetolactate synthase alS gene selection) (Bower et al. 2012). T. reesei strains were routinely cultivated at 30 °C in the presence of light.
Table 1.
Fungal strains and plasmids used in this study
| Genotype or description | Source or reference | |
|---|---|---|
| Fungal strains | ||
| QM6a | Wild-type strain | Anderson et al. 2013 |
| P37∆cbhIpyrG-26 | pyr4 − and PcbhI− | DuPont bioscience. Leiden, The Netherlands |
| JP7.7 | P37∆cbhIpyrG-26 with I-SceI restriction site cassette integrated at cbh2 locus | This study |
| JP7.7_pTTT | JP7.7+ pTTT | This study |
| JP7.7.12 | JP7.7+ pTTT-ISceI | This study |
| JP7.7.14 | JP7.7+ pTTT-ISceI | This study |
| Plasmids | ||
| pBJP6 | Carries a I-SceI restriction site cassette | This study |
| pCRpyrGAN | Contains the full gene of A. nidulans pyrG | This study |
| pTTT | cbhI promoter and amdS selection | DuPont bioscience |
| pTTT-ISceI | I-SceI under control of the inducible cbh1 promoter with amdS selection | This study |
| Ptrex6gGA/wt | Carries the T. reesei glucoamylase gene | DuPont bioscience |
| pJP8 | Carries a T. reesei glucoamylase cassette with homologous regions of the I-SceI landing sites cassette (pBJP6) | This study |
T. reesei was transformed using the polyethylene glycol (PEG)-mediated protoplast transformation protocol described by Penttilä et al. (1987) with slight modifications. Fifty-millilitre cultures inoculated with 5 × 108 conidia were grown in the dark at 30 °C and 200 rpm for 12–20 h. A total of 675 mg lysing enzyme (Sigma-Aldrich, Zwijndrecht, The Netherlands) were dissolved in 15 mL of 1.2 M MgSO4-10 mM sodium phosphate buffer, pH 5.8. Protoplasting was performed at 25 °C and 90 rpm and was verified every 30 min by microscopy. Two hundred microlitres of protoplast suspension was mixed with 5–10 μg of DNA and 2 mL of freshly made PEG buffer. Stable transformants were obtained by streaking on TrMM plates containing the required selection pressure, for two successive rounds. Single colonies obtained after double streaking were selected for sporulation and further analysis.
T. reesei liquid cultures were grown in 24-well plates configured such as to release lactose from a solid, porous matrix. Each well contained 1.25 mL of an NREL medium (9 g/L casamino acids, 5 g/L (NH4)2SO4, 4.5 g/L KH2PO4, 1 g/L MgSO4·7H2O, 1 g/L CaCl2·2H2O, 33 g/L PIPPS buffer, at pH 5.5, 0.25 % T. reesei trace elements, as described above). Escherichia coli DH5α strain was used for plasmid construction and propagation using standard techniques.
DNA manipulations and molecular analyses
Genomic DNA extraction of T. reesei, diagnostic PCR and Southern blot analysis were performed as previously described (Meyer et al. 2010). Restriction enzymes and DNA dephosphorylation and ligation kits were obtained from Invitrogen (Bleiswijk, The Netherlands) or Thermo Fisher (Leusden, The Netherlands) and used according to the instructions of the manufacturer. Sequencing was performed by Macrogen (Amsterdam, The Netherlands).
Construction of the I-SceI restriction site cassette
The plasmid pBJP6 with two I-SceI restriction sites was made as follows (Fig. S1 in the Supplementary Material). The 5′UTR cbh2, PcbhI and Tcbh2 were amplified from genomic DNA of QM6a with primers GSP1 and GSP2, PP1 and PP2, and GSP3 and GSP4, respectively (Table 2). The PCR fragments were fused using Phusion DNA polymerase (Thermo Fisher, Leusden, The Netherlands) and cloned into XbaI and KpnI sites of pBluescriptSK(+) (Stratagene, CA, USA) resulting in the plasmid pBJP4 (Fig. S1 in the Supplementary Material). DNA sequences encoding for N-terminally and C-terminally truncated green fluorescent protein (GFP) with 0.6-kbp overlapping sequences were synthetically ordered based on the GFP sequence of Ptilosarcus sp. (Geneart, Regensburg, Germany) and cloned into the NdeI site of pBJP4, resulting in the plasmid pBJP5. Restriction analysis was performed to ensure that the N-terminal sequence of GFP which contains the start codon is inserted properly after the promoter cbhI. The final pBPJ6 plasmid was obtained by amplifying the pyrG marker of Aspergillus nidulans flanked by two I-SceI sites with the primers FwpGAN-ISceIPmeI and RevpGAN-ISceIPmeI from the plasmid pCRpyrGAN and cloned into the PmeI site of pBJP5. pCRpyrGAN is a pCR-Topo Blunt-based vector with the kanamycin resistance marker containing a PCR-amplified 1.7-kb genomic DNA fragment of the A. nidulans pyrG gene. Primers FwpGAN-ISceIPmeI and RevpGAN-ISceIPmeI were designed to incorporate the I-SceI restriction sites and the PmeI sites downstream and upstream of the pyrG marker during PCR amplification (see primers sequences in Table 2). The sequence of the pBJP6 plasmid was confirmed by restriction analysis and sequencing.
Table 2.
List of primers used in this study
| Primer name | f/r | Sequence (5′ to 3′oriented) | Template |
|---|---|---|---|
| GSP1 (XbaI) | f | TCTAGAGGCTGTGCATTTCCGTTCTC | gDNA QM6a |
| GSP2 | r | TGGTTACGGCAACAAACCTG | gDNA QM6a |
| PP1 | f | CAGGTTTGTTGCCGTAACCAATTTGCCTGCTTGACCGACTG | gDNA QM6a |
| PP2 | r | GGAACGATGGGTTTGCGTCCATATGGGGTAAGTCACTTACGGCAGC | gDNA QM6a |
| GSP3 (NdeI) | f | CCATATGGACGCAAACCCATCGTTCC | gDNA QM6a |
| GSP4 (KpnI) | r | GGTACCGGTTCACCGCCTTATGTGAG | gDNA QM6a |
| FwpGAN-ISceI(PmeI) | f | GGTTTAAACCTAGGGATAACAGGGTAATTCGCCCTTGCTCTAGATAAC | pCRpyrGAN |
| RevpGAN-ISceI(PmeI) | r | GGTTTAAACCTAGGGATAACAGGGTAATAATTCGCCCTTGACTAGTGC | pCRpyrGAN |
| GSP5 (AsiSI) | f | GCGATCGCACGCAAACCCATCGTTCC | gDNA QM6a |
| GSP6 (AsiSI) | r | GCGATCGCGGTTCACCGCCTTATGTGAG | gDNA QM6a |
Underlined sequences within the primers denote the I-SceI restriction site
Construction of the I-SceI expression vector
A codon-optimized gene coding for the Saccharomyces cerevisiae I-SceI sequence (SGD ID S000007279) was synthesized for expression in T. reesei (Geneart, Regensburg, Germany). The nucleotide sequence encoding I-SceI has been deposited in GenBank under accession number KR584660. To construct a I-SceI expression vector, the I-SceI gene was cloned via a Gateway recombination into the telomeric plasmid pTTT (Aehle et al. 2011), where I-SceI expression was driven by the T. reesei cbhI-inducible promoter. A I-SceI variant in which we included the nuclear localization signal (NLS) (MATPSSVASS SSRDQVQRIH RVTRENRHLW YQLTVLQQPE RARACGSG) of the T. reesei Velvet protein (JGI ID 122284) was constructed and tested in parallel. To identify this putative NLS sequence in the T. reesei Velvet protein, the putative NLS sequence identified in the Velvet protein of A. nidulans (Stinnett et al. 2007) was used for alignments.
Construction of the glucoamylase expression cassette for targeted integration
The plasmid pTrex6g-GA (Bower et al. 2012), which harboured the wild-type glucoamylase gene of T. reesei under control of the cbhI promoter, was used to construct the glucoamylase expression cassette for integration at the I-SceI landing sites. To allow homologous integration of this reporter, the cbh2 terminator region (Tcbh2) was cloned in pTrex6g-GA. The Tcbh2 was amplified by PCR using the primers GSP5 and GSP6 (Table 2) and the genomic DNA of the T. reesei QM6a WT strain. The PCR product was digested with AsiSI and cloned into the same restriction sites of pTrex6g-GA, to form plasmid pJP8. The 10-kb glucoamylase expression fragment was cut out from pJP8 with PsiI and used for transformation.
In vivo analysis of I-SceI activity in T. reesei and fluorescent microscopy
Purified T. reesei transformants that carried I-SceI restriction sites and the I-SceI expression cassette were point inoculated on TrMM with 2 % of glucose or lactose as a carbon source with or without addition of uridine to the medium. The activity of I-SceI was monitored by formation of sectors without growth after incubating transformants for several days at 30 °C. Sector formation is likely to be the consequence of excision of the pyrG marker and subsequent repair of the genomic DNA induced by the I-SceI-mediated DSB. Transformants that formed sectors on solid medium were selected for GFP expression under fluorescence microscopy. A total of 107 conidia of sector-forming transformants were inoculated in 5-mL germination medium containing 2 % glucose/sophorose (30:1) for induction and supplemented with 0.003 % yeast extract and 10 mM uridine, and cultivated on cover slips for 28 h at 30 °C. Samples were observed with Axioplan 2 fluorescence microscope (Zeiss, Sliedrecht, The Netherlands) equipped with a DKC-5000 digital camera (Sony) using different contrast or GFP settings. Images were captured and processed using Adobe Photoshop 6.0 (Adobe Systems Inc.).
Quantification of the efficiency of pyrG excision mediated by I-SceI expression
To determine the frequency of the pyrG marker loss as a consequence of I-SceI expression, the strain JP7.7.12 bearing the I-SceI restriction sites and the I-SceI expressing cassette (pTTT-ISceI) was used. As a control, strain JP7.7_pTTT bearing the I-SceI restriction sites and the pTTT plasmid without I-SceI was included. About 100 spores of each strain harvested from minimal medium without uridine were grown separately under inducing conditions (TrMM with 2 % lactose as carbon source) supplemented with uridine. Addition of uridine into the medium allowed for growth of all spores including those that will lose the pyrG marker under I-SceI expression conditions. To quantify the frequency of the pyrG loss events, single colonies from I-SceI-induced medium were transferred into minimal medium with and without uridine. The efficiency of the marker excision was determined as the ratio of the number of pyrG-negative colonies and the total number of colonies grown on the plate with uridine.
Determination of glucoamylase activity and glucoamylase levels
Purified transformants were grown in production medium for 5 days and glucoamylase was measured from the culture filtrate. The activity of glucoamylase was determined using Betamyl as a substrate (Megazyme International, Bray, Ireland). Ten microlitres of the culture samples containing glucoamylase were mixed with 90 μL of Betamyl diluted in 50 mM sodium acetate pH 4.8. The reaction is performed at 37 °C for 20 min and quenched with 50 μL of 1 M sodium carbonate pH 9. Activity was monitored by the release of p-nitrophenol measured colorimetrically at 405 nm. For each transformant, the glucoamylase activity was measured in triplicate. Glucoamylase levels were detected using 10 % sodium dodecyl sulfate-polyacrylamide gel electrophoresis (SDS-PAGE) performed under denaturing conditions according to Laemmli (1970). Gels were stained with Coomassie Brilliant Blue R-250 (Bio-Rad, Veenendaal, The Netherlands).
Results
Design of a marker excision method to monitor I-SceI activity
With the aim to generate I-SceI-mediated double-strand DNA breaks at a predetermined site in the T. reesei genome for targeted integration, we first wished to make sure that the expression of the S. cerevisiae gene encoding I-SceI results in an active protein. To monitor the activity of the I-SceI meganuclease in T. reesei, a reporter construct that contained two I-SceI recognition sites flanking the A. nidulans pyrG selective marker was designed (Fig. 1). In addition, DNA with GFP direct repeats encoding an N-terminally (ΔNGFP) and C-terminally (GFPΔC) truncated, non-functional GFP were inserted around the I-SceI-pyrG-I-SceI sequence to provide regions for homologous recombination. Transcription of the GFPΔC part was regulated by the cbhI promoter. The pCbh1-GFPΔC-I-SceI-pyrG-I-SceI-ΔNGFP construct was subsequently cloned between ~1.5 kb 5′ and 3′ regions of the cbh2 gene (0.6 kb in length) for targeted integration at the cbh2 locus. The rationale of the strategy is that active I-SceI expressed in a T. reesei strain containing this reporter construct would result in excision of the pyrG marker and repair of the double-strand break via the GFP repeats. A perfect repair would result in a uridine-auxotrophic strain expressing GFP (Fig. 1). It should be noted that the genome of T. reesei does not naturally contain a I-SceI restriction site (5′-TAGGGATAACAGGGTAAT-3′).
Fig. 1.
Schematic representation of the strategy to test the double-strand break (DSB) activity of I-SceI expressed in T. reesei. The reporter cassette (pBJP6) with I-SceI restriction sites inserted at the cbh2 locus of a T. reesei uridine auxotrophic strain results in a uridine prototrophic strain containing two I-SceI sites surrounding the pyrG cassette (a). Heterologous expression of I-SceI is expected to generate two DSBs and the loss of the pyrG selection marker between the I-SceI sites (b). The DSB can be repaired by homologous recombination between GFP∆C and ∆NGFP adjacent to the breaks (c). After homologous recombination via the GFP direct repeats, this will result in a uridine auxotrophic strain (loss of the pyrG gene) and reconstitution of a functional GFP when correctly recombined via the direct repeat sequences (d). The resulting strain can be either screened for uridine auxotrophy or/and for GFP expression to monitor I-SceI activity
Construction of a T. reesei strain harbouring the I-SceI restriction sites at the cbh2 locus
The 7.5-kb reporter cassette as described above was linearized and introduced into a T. reesei strain deleted for cbhI. Transformants were analysed by Southern blot for correct integration at the cbh2 locus. Southern blot analysis revealed three transformants harbouring a single copy of the complete I-SceI cassette at the cbh2 locus (JP7.7, JP7.9 and JP7.12) (Fig. S2 in the Supplementary Material). Other transformants either had multiple copies of the cassette integrated (JP7.10, JP7.11, JP7.13, JP7.14 and JP7.15) or did not seem to insert the complete cassette into the genome (JP7.8) (Fig. S2 in the Supplementary Material). Transformant JP7.7 was used in subsequent experiments.
I-SceI expression in T. reesei induces DSB at the targeted chromosomal locus
A codon-optimized version of I-SceI with or without an additional NLS sequence from the T. reesei vel1 gene was introduced on a replicative plasmid into JP7.7 strain bearing the I-SceI landing sites. Expression of I-SceI nuclease was controlled by the cbh1 promoter, which is repressed by glucose and strongly induced by lactose or sophorose (Ivanova et al. 2013; Xu et al. 2014). Transformants were grown either on glucose- or lactose/glucose-containing medium. As shown in Fig. 2, induction by lactose in the strains expressing I-SceI and containing the I-SceI reporter cassette resulted in sectored colonies. This sectoring could be interpreted as I-SceI activity generating a double-strand break, which was repaired via recombination between the GFP direct repeats leading to loss of the pyrG marker. As a consequence of efficient recombination in all nuclei in some part of the colony, this part of the colony no longer grew on plates without uridine giving rise to a non-growing sector. As shown in Fig. 2, sectors were present when lactose was used as a carbon source, although we occasionally (less than 10 % of the glucose/lactose plates) also observed sectors on glucose plates indicating that some I-SceI might be expressed (not shown). No sectors were observed in the control strains (JP7.7) or JP7.7 containing the empty vector (JP7.7+ pTTT), indicating the SceI expression is required for looping out the pyrG marker. Similar sectoring on lactose was observed for transformants expressing I-SceI with NLSvel1 but never for the control strains (Fig. 2 and data not shown). When uridine was added to the plates, non-growing sectors were absent indicating that they were caused by loss of the pyrG marker (Fig. 2). These results strongly suggest that the S. cerevisiae I-SceI was expressed and active in T. reesei.
Fig. 2.

Loss of the pyrG cassette is mediated via I-SceI meganuclease-induced loop-out recombination control strain (P37∆cbhIpyrG-26), and strains harbouring the I-SceI restriction site-containing construct (JP7.7 transformants) were transformed with either the control plasmid (pTTT) or the I-SceI expression plasmid (pTTT-ISceI). Spores of the strains were point-inoculated in the centre of a 9-cm Petri dish containing minimal medium and containing either 50 mM glucose (glucose) or a mix of 50 mM glucose and 50 mM lactose (glucose and lactose) either with or without the addition of uridine. Pictures of the colonies were taken after 4 days of growth at 30 °C. Induction of I-SceI expression by lactose in JP7.7 transformants containing the pTTT-ISceI vector results in sectored colonies. These sectors are regions of no growth expected to be caused by loop out of the pyrG marker and the subsequent inability of the strain to grow on the medium without uridine. Sectoring is dependent on the expression of I-SceI via lactose induction and no longer visible if uridine is supplemented. Arrows indicate regions with no growth. As expected, the parental strain does not grow on media without uridine
Functionality of I-SceI was further confirmed by fluorescent microscopy in liquid cultures. Hyphae grown in the presence of sophorose showed green fluorescence indicating reconstitution of a functional GFP as a consequence of the pyrG excision followed by a recombination event. As GFP was observed only in strains expressing I-SceI, this further indicates that I-SceI was actively expressed (Fig. 3).
Fig. 3.

Visualization of GFP fluorescence after I-SceI meganuclease-mediated loop-out recombination. Induction of I-SceI expression by sophorose results in excision of the pyrG marker and reconstitution of a functional GFP, indicated by the green fluorescent hyphae. Strains were grown on TrMM containing 2 % glucose/sophorose (30:1) and uridine to induce I-SceI expression and allow the loss of the pyrG marker, respectively. Strain JP7.7, harbouring I-SceI restriction sites but not expressing the I-SceI gene, was included in the analysis. Lack of GFP expression indicates that the loop-out event to restore GFP functionality requires I-SceI. Bars, 10 μm
The frequency of the I-SceI-mediated excision was determined by comparing the frequency of losing the pyrG marker in the I-SceI-expressing and I-SceI-non-expressing strains (strains JP7.7.12 and JP7.7_pTTT, respectively). Therefore, about 100 spores of each strain were plated on lactose-containing induction medium supplemented with uridine. After growth for 3 days, each colony formed was further scored for its growth in the absence of uridine. Sixty-six percent of the colonies of the JP7.7.12 strain bearing the I-SceI restriction sites and containing the I-SceI expression cassette (pTTT-ISceI) were found to be auxotrophic for uridine, whereas only 1.3 % of the colonies of JP7.7_pTTT strain bearing the empty pTTT plasmid were uridine-dependent. Thus, a high frequency of pyrG excision mediated by in vivo-expressed I-SceI nuclease was observed during a plate growth test.
I-SceI-mediated DSB increases transformation efficiency and transformant stability
To determine whether a DSB mediated by I-SceI can increase transformation and recombination efficiency in T. reesei, the aforementioned reporter strain JP7.7.12 was transformed with a linear fragment comprising a glucoamylase expression cassette (Fig. 4). This cassette contains the alS selection marker which renders transformations to become resistant against chlorimuron ethyl (Bower et al. 2012). Chlorimuron ethyl-resistant transformants were selected either on glucose (I-SceI-repressed conditions) or lactose- and glucose-containing medium (I-SceI-inducing condition). As a control, we also transformed a strain carrying only the I-SceI restriction sites (JP7.7) with the same DNA fragment. As shown in Fig. 5 and Table 3, I-SceI induction increased the number of chlorimuron ethyl-resistant transformants more than threefold and sixfold as compared to repressed conditions and to the control, respectively.
Fig. 4.
Schematic representation of targeted integration of the glucoamylase expression cassette via I-SceI-mediated homologous recombination. (a) As a starting strain, the same reporter strain (JP7.7) was used as before. This strain contains the cassette with the I-SceI restriction sites inserted at the cbh2 locus of T. reesei. (b) Transformation of JP7.7 with the vector to express the I-SceI gene (pTTT-ISceI). This strain can be propagated on glucose medium without uridine to keep selection pressure on maintaining the pyrG cassette. (c and d) Transformation of the glucoamylase-expressing cassette (pJP8) and simultaneous induction of I-SceI expression to create a DSB. I-SceI was induced by plating out protoplasts on lactose-containing transformation plates. The DSB can be repaired by homologous recombination with the glucoamylase-expressing cassette (pJP8), which has homology regions to the locus containing the I-SceI sites. (e) Targeted integration of the glucoamylase cassette at the I-SceI landing site would generate a strain that is resistant to chlorimuron ethyl (alS +) and uridine auxotrophic (pyrG −) and is expected to contain the glucoamylase gene under control of the cbhI promoter
Fig. 5.
Transformation under I-SceI-inducing and non-inducing conditions. The glucoamylase-expressing cassette (pJP8) with homologous regions to the locus containing the I-SceI restriction sites was transformed into the parental strain (P37), JP7.7 (containing the I-SceI restriction site construct) and JP7.7.12 (containing the I-SceI restriction site construct and expressing I-SceI), respectively, by PEG transformation. The protoplasts were plated out on glucose- or lactose/glucose-based transformation medium supplemented with chlorimuron ethyl and uridine. Transformants were photographed after 3 days of incubation
Table 3.
The effect of I-SceI induction on number and stability of transformants
| Strain | C source | # of primary transformantsa | % stable transformantsb | % Gla-positive transformantsc | % Gla-positive pyrG − transformantsd | Homologous recombination efficiencye |
|---|---|---|---|---|---|---|
| JP7.7 (Control) | Lactose | 32 | 17/32 (53 %) | Not tested | Not tested | Not tested |
| JP7.7 (Control) | Glucose | 36 | 21/36 (58 %) | 12/40 (30 %) | 2/12 (16 %) | 2/12 (16 %) |
| JP7.7.12 (pTTT-ISceI) | Lactose | >226 | 45/50 (90 %) | 22/40 (55 %) | 15/22 (68 %) | 15/22 (68 %) |
| JP7.7.12 (pTTT-ISceI) | Glucose | 70 | 22/50 (44 %) | 15/40 (37 %) | 7/15 (46 %) | 7/15 (46 %) |
aNumber of primary transformants on transformation plates (TrMMsorb + uridine + chlorimuron ethyl (Als substrate)) containing 1 % of lactose and 1 % glucose referred to as induced and non-induced expression of I-SceI, respectively. Control transformations have been carried out using the transformation medium using the parental strain JP7.7.
bPrimary transformants were purified on TrMM + uridine + chlorimuron ethyl. The stability of the transformants is defined by their ability to grow in selective TrMM after double purification. Stable transformants grow well on these selective plates. Abortive transformants (not stable) do not grow
cStable transformants were tested for glucoamylase activity in a microtitre-based growth/activity assay. Transformants showing Gla activity above the background were considered as Gla-positive transformants
dGla-positive transformants were tested for the pyrG phenotype by inoculating spores of each transformant on TrMM with uridine or TrMM without uridine. Strains were considered pyrG minus (uridine auxotroph) when growing on TrMM + uridine, but not growing om TrMM without uridine
eGlaA expressing and pyrG minus strain were analysed by Southern blot and confirmed an integration pattern indicative of homologous integration of the glaA expression cassette at the I-SceI landing site
We further analysed the stability of the transformants obtained in each group of transformation, as by subsequent purification on MM-chlorimuron ethyl plates. Ninety percent of the transformants obtained after the induction of I-SceI were stable against 44 and 58 % of colonies grown under repressed conditions and for the control strain, respectively (Table 3). This indicates that heterologous expression of the I-SceI nuclease increased transformation efficacy and transformant stability. Instability of transformants usually results from a lack of integration of a given DNA cassette into the genome and has been previously described to be a major bottleneck for T. reesei transformation (Jørgensen et al. 2014).
Targeted integration of the glucoamylase expression cassette at the predetermined genomic locus would result in acquisition of chlorimuron ethyl resistance (alS+ phenotype), uridine auxotrophy, caused by a loss of the pyrG marker, and the presence of the glucoamylase expression cassette (Fig. 4). To determine whether the I-SceI-mediated targeted integration correlated with the expression of the introduced glucoamylase cassette, we assayed ~40 stable transformants from each transformation group for glucoamylase activity and screened the glucoamylase-positive transformants for their pyrG phenotype. As shown in Table 3, about two thirds of the glucoamylase-positive transformants (15 of 22) obtained upon I-SceI induction became uridine-auxotrophic, indicating that the construct was integrated at the intended locus via a double-crossover event, thereby removing the pyrG marker. Frequencies of homologous recombination were ~46 and ~16 % under I-SceI repression and in the control strain, respectively. These results show that expression of I-SceI increased both the transformation efficiency and the frequency of targeted integration in T. reesei. Leaky expression from the cbhI promoter in glucose medium could explain the increased number of targeted integration transformants under repressed conditions, as compared to the control transformants. Overall analysis showed that ~93 % (14/15) uridine-requiring strains expressed glucoamylase when I-SceI was induced, thereby confirming strong correlation between a pyrG-negative phenotype and glucoamylase expression. We further analysed genomic DNA from selected transformants for the integration pattern of the glucoamylase cassette by Southern blot. The uridine-auxotrophic transformants expressing glucoamylase contained the complete glucoamylase cassette integrated in a single copy at the predetermined cbh2 locus (Fig. 6a, b). PyrG+ transformants not showing glucoamylase activity very likely did not or only partially integrated the glucoamylase cassette. PyrG+ transformants displaying glucoamylase activity resulted probably from a partial integration of the cassette with the intact glucoamylase gene into the genome (Fig. 6a, b; PCR, data not shown).
Fig. 6.
Southern blot analysis of selected transformants after transformation with the glucoamylase expression cassette. a Diagram of pJP8 transformants to analyse integration of the glucoamylase cassette at the 5′ flank and 3′ flank of the cbh2 locus by using SpeI and BamHI as restriction enzymes and PcbhI and Tcbh2 as probes, respectively. The expected band size is 5.4 kb for integration of the glucoamylase cassette using the PcbhI probe and 6.8 kb for integration using the Tcbh2 probe. A non-homologous integration of the glucoamylase cassette will not alter the cbh2 locus and a hybridizing DNA fragment of 3.6 and 3 kb are expected with the PcbhI probe and the cbh2 probe, respectively. b Southern blot results of pJP8 transformants to analyse the integration of the glucoamylase cassette at the 5′ flank (left blot) and 3′ flank (right blot) of the cbh2. The two blots shown for analysis of the 5′ flank integration or 3′ flank integration are from a single Southern blot. Some lanes of the blot have been removed to exclude unrestricted genomic DNA samples. I I-SceI is induced, R I-SceI is repressed, + indicate presence of pyrG marker or glucoamylase expression, − indicate absence of the pyrG marker or non-expression of glucoamylase
Uniform expression of the reporter glucoamylase gene after targeted integration at the engineered genomic locus
To compare the variability in glucoamylase (GA) expression among transformants with targeted integration of the GA cassette (pyrG− transformants) versus random integrated transformants (pyrG+ transformants), strains were grown in sophorose-containing medium to induce GA, and culture samples were assayed for glucoamylase activity. As shown in Fig. 7, pyrG− transformants obtained displayed a more consistent pattern of glucoamylase activity as compared to the expression profile of pyrG+ transformants. Nearly 80 % of transformant GA activity varied within a range of 15–20 %, which could be explained by a single-copy integration of the GA fragment at the engineered locus. The variation observed resulted from fermentation conditions rather than differences in the genetic background of the transformants. In contrast, a random integration of the expression cassette gave rise to significant variation in GA levels among transformants (Fig. 7). On average, the transformant obtained by random integration displayed lower glucoamylase activity than the transformant obtained by targeted integration and could be due to the targeting of the expression cassette to the cbh2 locus, which is likely to be an actively transcribed region with a positive effect on glucoamylase production which is driven by the cbh1 promoter.
Fig. 7.
Glucoamylase activity in culture medium of transformants obtained after targeted or random integration. Targeted integrated transformants displayed high homogeneity of glucoamylase activity compared to transformants with random integration of the glucoamylase cassette. The analysed transformants were tested based on their auxotrophy to uridine. The targeted (n = 23) and random (n = 26) integrated transformants are pyrG − and pyrG + phenotype, respectively. The pyrG − transformants were further characterized for correct targeting of the glucoamylase cassette at the cbh2 locus. Plots were created using GraphPad Prism 6 (column scatter graph). The horizontal bars represent the mean values with standard deviations
Discussion
Rare-cutting, double-stranded DNA endonucleases, called meganucleases, have emerged as a powerful tool for genome manipulation. Several studies have demonstrated that expression of such endonucleases in prokaryotic and eukaryotic cells stimulated homologous recombination between a given repair template and a genome locus containing an endonuclease recognition site (Choulika et al. 1995; Glover and Horn 2009; Meddows et al. 2005; Rouet et al. 1994). The aim of the current study was to increase efficiency of the gene-targeted integration at a predetermined locus in the T. reesei genome to ensure high expression levels and limited variability of protein expression. To this end, the S. cerevisiae endonuclease I-SceI was expressed in T. reesei and I-SceI recognition sites flanking a reporter construct were introduced into the cbh2 locus of T. reesei. We demonstrated that expression of I-SceI resulted in endonuclease activity. The I-SceI protein appeared to be imported into the T. reesei nucleus via the intrinsic NLS signal, as we did not detect obvious differences in efficiency of marker excision between the original I-SceI protein and a I-SceI variant fused to a nuclear targeting signal of the T. reesei Vel1 protein. We analysed the impact of the I-SceI-mediated DSBs on transformation frequency, transformant stability and efficiency of homologous recombination.
Our data indicate that DSB mediated by I-SceI in T. reesei improves the efficiency of transformation and the stability of the transformants and promotes gene targeting at a defined locus. At least sixfold more transformants were obtained when I-SceI was induced, and, more importantly, 90 % of them were found to be stable. Genetic instability is a major bottleneck in T. reesei transformation and usually is a consequence of a lack of integration of a transformed DNA cassette into the genome or due to a tandem integration of multiple copies, which could be excised through a loop-out event (Aw and Polizzi 2013; Jørgensen et al. 2014; Le Dall et al. 1994; Lee and Da Silva 1997; Ohi et al. 1998). This is the first study that addresses issues related to the stability of transformants mediated by I-SceI in filamentous fungi and particularly in the industrial fungus T. reesei. Furthermore, when I-SceI was expressed in the cells, the frequency of homologous recombination increased up to 68 %.
A recent study of gene targeting based on I-SceI-induced DSBs in P. oryzae (Magnaporthe oryzae) reported that in this fungus, I-SceI expression increases targeted integration up to about 40 %, which is comparable to our findings (Arazoe et al. 2014). Targeted integration can be also improved in filamentous fungi by deletion of the genes involved in non-homologous end joined (NHEJ) recombination (Ninomiya et al. 2004; Krappmann et al. 2006; Meyer et al. 2007; Guangtao et al. 2009; Steiger et al. 2011). However, inactivation of the NHEJ genes usually increases strain sensitivity towards chemicals and physical DNA-damaging agents and mostly reduces efficiency of transformation as compared to a strain with intact NHEJ genes (Zhang et al. 2011). In addition, targeted integration in strains deficient of NHEJ proteins can be highly locus-dependent and may vary from 33 to 100 % depending on the insertion site (Jørgensen et al. 2014; Schuster et al. 2012). Our study shows that using the I-SceI endonuclease, we can improve targeted integration events in a T. reesei strain with intact NHEJ genes. Moreover, the targeted integration transformants could be specifically selected by adding 5-fluoroorotic acid (5′FOA) in the transformation medium. About 90 % of the pyrG− transformants expressed glucoamylase, indicating that the DNA cassette was integrated at the intended locus. Moreover, Southern blot analysis confirmed the presence of a single copy of the expression fragment in these transformants. Importantly, we found that glucoamylase production levels were much more consistent among the transformants that harboured the expression cassette at the targeted locus as compared to transformants with a random integration pattern. Homogeneity in protein expression in the population of transformants is always a great challenge in the field of fungal biotechnology because of the low efficiency of targeted integration events (Aw and Polizzi 2013). Thus, our technique may be employed for high-throughput screening of enzyme libraries or for construction of production strains with predetermined integration sites, which is especially relevant in industrial biotechnology.
Electronic supplementary materials
(PDF 294 kb)
Acknowledgments
We thank Prof. Dr. Paul Hooykaas and Dr. Jaap Visser for the helpful discussions. We thank Dr. F. Klis for carefully reading the manuscript. This project was carried out within the research programme of the Kluyver Centre for Genomics of Industrial Fermentation, which is part of The Netherlands Genomics Initiative/Netherlands Organization for Scientific Research.
Conflict of interest
The authors declare that they have no competing interests.
Compliance with ethical standards
This article does not contain any studies with human participants or animals performed by any of the authors.
References
- Adrio JL, Demain AL. Microbial enzymes: tools for biotechnological processes. Biomolecules. 2014;4:117–139. doi: 10.3390/biom4010117. [DOI] [PMC free article] [PubMed] [Google Scholar]
- Aehle, W, Bott, RR, Nikolaev, I, Scheffers, M, van Solingen, P, Vroemen, C (2011) Glucoamylase variants with altered properties. Patent US20110020899. Accessed 27 January 2011
- Anderson LN, Culley DE, Hofstad BA, Chauvigné-Hines LM, Zink EM, Purvine SO, Smith RD, Callister SJ, Magnuson JM, Wright AT. Activity-based protein profiling of secreted cellulolytic enzyme activity dynamics in Trichoderma reesei QM6a, NG14, and RUT-C30. Mol BioSyst. 2013;9:2992–3000. doi: 10.1039/c3mb70333a. [DOI] [PMC free article] [PubMed] [Google Scholar]
- Arazoe T, Younomaru T, Ohsato S, Kimura M, Arie T, Kuwata S. Site-specific DNA double-strand break generated by I-SceI endonuclease enhances ectopic homologous recombination in Pyricularia oryzae. FEMS Microbiol Lett. 2014;352:221–229. doi: 10.1111/1574-6968.12396. [DOI] [PubMed] [Google Scholar]
- Aw R, Polizzi KM. Can too many copies spoil the broth? Microb Cell Factories. 2013;12:128. doi: 10.1186/1475-2859-12-128. [DOI] [PMC free article] [PubMed] [Google Scholar]
- Bollag RJ, Waldman AS, Liskay RM. Homologous recombination in mammalian cells. Annu Rev Genet. 1989;23:199–225. doi: 10.1146/annurev.ge.23.120189.001215. [DOI] [PubMed] [Google Scholar]
- Bower BS, Dunn-Coleman N, Leiva N (2012). Acetolactate synthase (ALS) selectable marker from Trichoderma reesei. Patents US8138321. Accessed 20 March 2012
- Cahill D, Connor B, Carney JP. Mechanisms of eukaryotic DNA double strand break repair. Front Biosci. 2006;11:1958–1976. doi: 10.2741/1938. [DOI] [PubMed] [Google Scholar]
- Catalano V, Vergara M, Hauzenberger JR, Seiboth B, Sarrocco S, Vannacci G, Kubicek CP, Seidl-Seiboth V. Use of a non-homologous end-joining-deficient strain (delta-ku70) of the biocontrol fungus Trichoderma virens to investigate the function of the laccase gene lcc1 in sclerotia degradation. Curr Genet. 2011;57:13–23. doi: 10.1007/s00294-010-0322-2. [DOI] [PMC free article] [PubMed] [Google Scholar]
- Choulika A, Perrin A, Dujon B, Nicolas JF. Induction of homologous recombination in mammalian chromosomes by using the I-SceI system of Saccharomyces cerevisiae. Mol Cell Biol. 1995;15:1968–1973. doi: 10.1128/MCB.15.4.1968. [DOI] [PMC free article] [PubMed] [Google Scholar]
- Fairhead C, Dujon B. Consequences of unique double-stranded breaks in yeast chromosomes: death or homozygosis. Mol Gen Genet. 1993;240:170–178. doi: 10.1007/BF00277054. [DOI] [PubMed] [Google Scholar]
- Glover L, Horn D. Site-specific DNA double-strand breaks greatly increase stable transformation efficiency in Trypanosoma brucei. Mol Biochem Parasitol. 2009;166:194–197. doi: 10.1016/j.molbiopara.2009.03.010. [DOI] [PMC free article] [PubMed] [Google Scholar]
- Guangtao Z, Hartl L, Schuster A, Polak S, Schmoll M, Wang T, Seidl V, Seiboth B. Gene targeting in a nonhomologous end joining deficient Hypocrea jecorina. J Biotechnol. 2009;139:146–151. doi: 10.1016/j.jbiotec.2008.10.007. [DOI] [PubMed] [Google Scholar]
- Ivanova C, Baath JA, Seiboth B, Kubicek CP (2013) Systems analysis of lactose metabolism in Trichoderma reesei identifies a lactose permease that is essential for cellulase induction. PLoS ONE 8:e62631. doi:10.1371/journal.pone.0062631 [DOI] [PMC free article] [PubMed]
- Jørgensen MS, Skovlund DA, Johannesen PF, Mortensen UH. A novel platform for heterologous gene expression in Trichoderma reesei (teleomorph Hypocrea jecorina) Microb Cell Factories. 2014;13:33. doi: 10.1186/1475-2859-13-33. [DOI] [PMC free article] [PubMed] [Google Scholar]
- Krappmann S, Sasse C, Braus GH. Gene targeting in Aspergillus fumigatus by homologous recombination is facilitated in a nonhomologous end-joining-deficient genetic background. Eukaryot Cell. 2006;5:212–215. doi: 10.1128/EC.5.1.212-215.2006. [DOI] [PMC free article] [PubMed] [Google Scholar]
- Kuijpers NG, Chroumpi S, Vos T, Solis-Escalante D, Bosman L, Pronk JT, Daran JM, Daran-Lapujade P. One-step assembly and targeted integration of multigene constructs assisted by the I-SceI meganuclease in Saccharomyces cerevisiae. FEMS Yeast Res. 2013;13:769–781. doi: 10.1111/1567-1364.12087. [DOI] [PMC free article] [PubMed] [Google Scholar]
- Laemmli UK. Cleavage of structural proteins during the assembly of the head of bacteriophage T4. Nature. 1970;227:680–685. doi: 10.1038/227680a0. [DOI] [PubMed] [Google Scholar]
- Le Dall MT, Nicaud JM, Gaillardin C. Multiple-copy integration in the yeast Yarrowia lipolytica. Curr Genet. 1994;26:38–44. doi: 10.1007/BF00326302. [DOI] [PubMed] [Google Scholar]
- Lee FW, Da Silva NA. Improved efficiency and stability of multiple cloned gene insertions at the Δ sequences of Saccharomyces cerevisiae. Appl Microbiol Biotechnol. 1997;48:339–345. doi: 10.1007/s002530051059. [DOI] [PubMed] [Google Scholar]
- Meddows TR, Savory AP, Grove JI, Moore T, Lloyd RG. RecN protein and transcription factor DksA combine to promote faithful recombinational repair of DNA double-strand breaks. Mol Microbiol. 2005;57:97–110. doi: 10.1111/j.1365-2958.2005.04677.x. [DOI] [PubMed] [Google Scholar]
- Meyer V, Arentshorst M, El-Ghezal A, Drews AC, Kooistra R, van den Hondel CA, Ram AF. Highly efficient gene targeting in the Aspergillus niger kusA mutant. J Biotechnol. 2007;128:770–775. doi: 10.1016/j.jbiotec.2006.12.021. [DOI] [PubMed] [Google Scholar]
- Meyer V, Ram AF, Punt PJ (2010) Genetics, genetic manipulation, and approaches to strain improvement of filamentous fungi. In: Demain AL, Davis J (eds) Manual of industrial microbiology and biotechnology, 3rd edn. John Wiley and Sons Inc, NewYork, pp 318-329
- Monteilhet C, Perrin A, Thierry A, Colleaux L, Dujon B. Purification and characterization of the in vitro activity of I-SceI, a novel and highly specific endonuclease encoded by a group I intron. Nucleic Acids Res. 1990;18:1407–1413. doi: 10.1093/nar/18.6.1407. [DOI] [PMC free article] [PubMed] [Google Scholar]
- Ninomiya Y, Suzuki K, Ishii C, Inoue H. Highly efficient gene replacements in Neurospora strains deficient for nonhomologous end-joining. Proc Natl Acad Sci U S A. 2004;101(33):12248–12253. doi: 10.1073/pnas.0402780101. [DOI] [PMC free article] [PubMed] [Google Scholar]
- Ohi H, Okazaki N, Uno S, Miura M, Hiramatsu R. Chromosomal DNA patterns and gene stability of Pichia pastoris. Yeast. 1998;14:895–903. doi: 10.1002/(SICI)1097-0061(199807)14:10<895::AID-YEA288>3.0.CO;2-9. [DOI] [PubMed] [Google Scholar]
- Penttilä M, Nevalainen H, Rättö M, Salminen E, Knowles J. A versatile transformation system for the cellulolytic filamentous fungus Trichoderma reesei. Gene. 1987;61:155–164. doi: 10.1016/0378-1119(87)90110-7. [DOI] [PubMed] [Google Scholar]
- Plessis A, Perrin A, Haber JE, Dujon B. Site-specific recombination determined by I-SceI, a mitochondrial group I intron-encoded endonuclease expressed in the yeast nucleus. Genetics. 1992;130:451–460. doi: 10.1093/genetics/130.3.451. [DOI] [PMC free article] [PubMed] [Google Scholar]
- Puchta H, Dujon B, Hohn B. Homologous recombination in plant cells is enhanced by in vivo induction of double strand breaks into DNA by a site-specific endonuclease. Nucleic Acids Res. 1993;21:5034–5040. doi: 10.1093/nar/21.22.5034. [DOI] [PMC free article] [PubMed] [Google Scholar]
- Rouet P, Smih F, Jasin M. Introduction of double-strand breaks into the genome of mouse cells by expression of a rare-cutting endonuclease. Mol Cell Biol. 1994;14:8096–8106. doi: 10.1128/MCB.14.12.8096. [DOI] [PMC free article] [PubMed] [Google Scholar]
- Schuster A, Schmoll M. Biology and biotechnology of Trichoderma. Appl Microbiol Biotechnol. 2010;87:787–799. doi: 10.1007/s00253-010-2632-1. [DOI] [PMC free article] [PubMed] [Google Scholar]
- Schuster A, Bruno KS, Collett JR, Baker SE, Seiboth B, Kubicek CP, Schmoll M. A versatile toolkit for high throughput functional genomics with Trichoderma reesei. Biotechnol Biofuels. 2012;5:1. doi: 10.1186/1754-6834-5-1. [DOI] [PMC free article] [PubMed] [Google Scholar]
- Steiger MG, Vitikainen M, Uskonen P, Brunner K, Adam G, Pakula T, Penttilä M, Saloheimo M, Mach RL, Mach-Aigner AR. Transformation system for Hypocrea jecorina (Trichoderma reesei) that favors homologous integration and employs reusable bidirectionally selectable markers. Appl Environ Microbiol. 2011;77:114–121. doi: 10.1128/AEM.02100-10. [DOI] [PMC free article] [PubMed] [Google Scholar]
- Stinnett SM, Espeso EA, Cobeno L, Araujo-Bazan L, Calvo AM. Aspergillus nidulans VeA subcellular localization is dependent on the importin α carrier and on light. Mol Microbiol. 2007;63:242–255. doi: 10.1111/j.1365-2958.2006.05506.x. [DOI] [PubMed] [Google Scholar]
- Szostak JW, Orr-Weaver TL, Rothstein RJ, Stahl FW. The double-strand-break repair model for recombination. Cell. 1983;33:25–35. doi: 10.1016/0092-8674(83)90331-8. [DOI] [PubMed] [Google Scholar]
- Turner NJ. Directed evolution drives the next generation of biocatalysts. Nat Chem Biol. 2009;5:567–573. doi: 10.1038/nchembio.203. [DOI] [PubMed] [Google Scholar]
- Xu J, Zhao G, Kou Y, Zhang W, Zhou Q, Chen G, Liu W. Intracellular β-glucosidases CEL1a and CEL1b are essential for cellulase induction on lactose in Trichoderma reesei. Eukaryot Cell. 2014;13:1001–1013. doi: 10.1128/EC.00100-14. [DOI] [PMC free article] [PubMed] [Google Scholar]
- Zhang J, Mao Z, Xue W, Li Y, Tang G, Wang A, Zhang Y, Wang H. Ku80 gene is related to non-homologous end-joining and genome stability in Aspergillus niger. Curr Microbiol. 2011;62:1342–1346. doi: 10.1007/s00284-010-9853-5. [DOI] [PubMed] [Google Scholar]
Associated Data
This section collects any data citations, data availability statements, or supplementary materials included in this article.
Supplementary Materials
(PDF 294 kb)